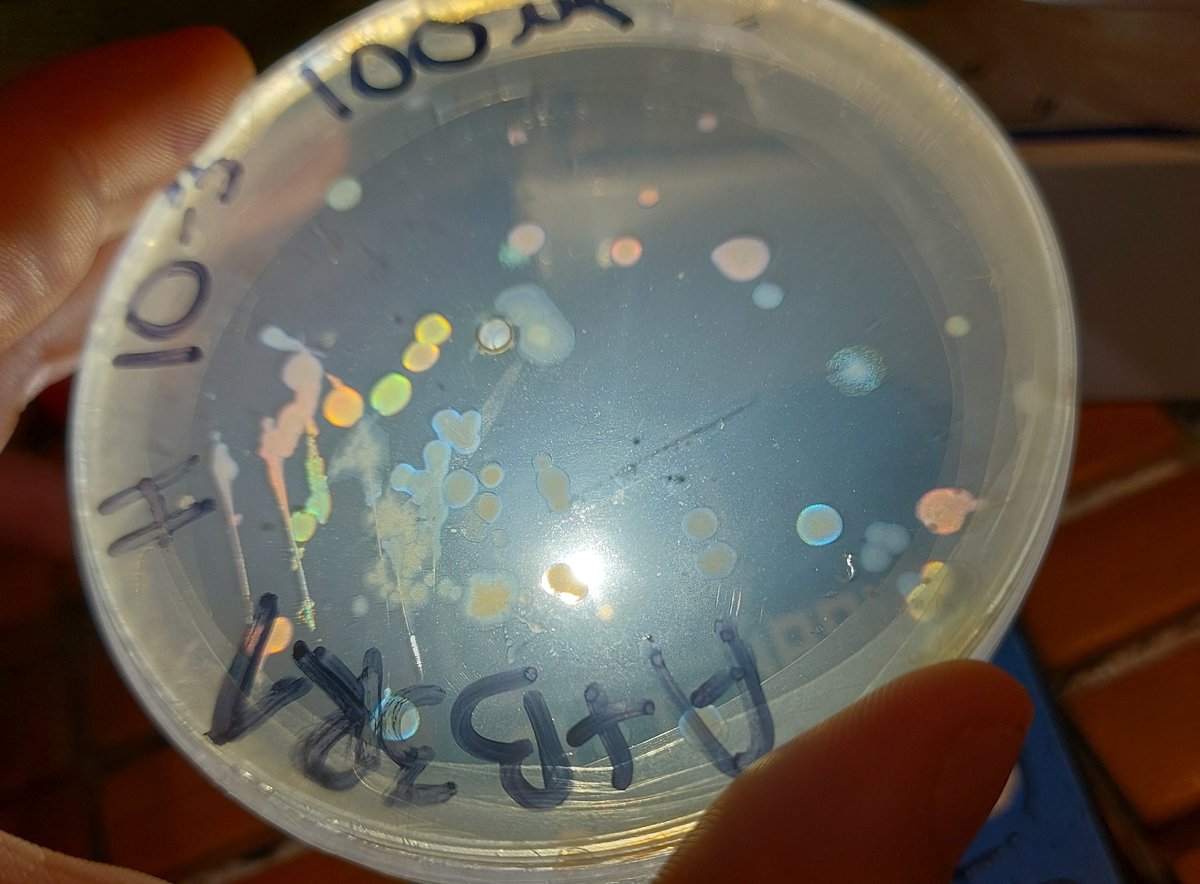
erickmoretau's tweet image. My friend showed me her culture, and I thought I saw something. First time I see #structuralcolor in bacteria live. I would like to transfer this skill to E. coli. Very complex knowledge and engineering are needed and far beyond my current capabilities. I am amazed by its beauty

#structuralcolor search results
🎨🌱Structural color provides a greener alternative to chemical textile dyes. Using polycatechin (PCC) nanofilms, this study produces bright, uniform, and controllable colors on silk fabrics through thin-film interference. 🔗 mdpi.com/2313-7673/9/1/… #Textiles #StructuralColor

光の当て方と角度で色が変わり 色が無くなります #構造色 #StructuralColor #artwork #フラクタル #みんなで楽しむTwitter展覧会 #ART祭 #芸術同盟 #ものづくり ♡いいねありがとうございます


My friend showed me her culture, and I thought I saw something. First time I see #structuralcolor in bacteria live. I would like to transfer this skill to E. coli. Very complex knowledge and engineering are needed and far beyond my current capabilities. I am amazed by its beauty

View Spotlight Analysis of the #OPG_JOSA_B paper Inverse-designed metasurfaces for highly saturated transmissive colors ow.ly/TNE450R1vOj Spotlight Summary by Filiz Yesilkoy #Metamaterials #StructuralColor

Structural color. Front and back of a Morpho butterfly. Bought in Cuzco, Peru. #StructuralColor #Biomimetics #interference #optics


Yesterday, I had the pleasure of meeting the students of the Collège St-Michel in Fribourg. My first scientific presentation in French about #StructuralColor in nature was very exciting. Thank you for the interesting questions! @NCCRbioinspired #Aresearcherinyourclass #NCCRWomen



🎉Mingzhu Li group at Institute of Chemistry, CAS, China developed a general multichannel information encryption strategy using a two-dimensional deformable kirigami arranging orientations of the grating arrays by design. #StructuralColor Paper 👉doi.org/10.1016/j.scib…

2018年の藝大女子会展の様子です。 #contemporaryart #artwork #StructuralColor #abstract #現代アート #アート好きな人と繋がりたい #絵描きさんと繋がりたい #私の個性はきっと誰かにささる #三億アカウントの中から私を発掘してください #みんなで楽しむTwitter展覧会 #芸術同盟 #芸術の輪

Via #OPG_OpEx: Tailoring resonant modes in dual cavities for transmissive structural colors with high brightness and high purity bit.ly/4bEYV8N #StructuralColor #SolarCells

Discover the fascinating science behind blueberry color. Learn how nature uses structural color for blueberries’ unique blue hue. Find out more with FreeAstroScience. #Blueberry #StructuralColor #Nature #BlueHues #Science #NaturalColors #Fruit Read.. freeastroscience.com/2024/11/why-ar…

An Editors' Pick via #OPG_OMEx: Photonic spheres by microgel templating [Invited] ow.ly/5FzI50QI30Z #StructuralColor #TemplatedAssembly @unifr
![OpticaPubsGroup's tweet image. An Editors' Pick via #OPG_OMEx: Photonic spheres by microgel templating [Invited] ow.ly/5FzI50QI30Z #StructuralColor #TemplatedAssembly @unifr](https://pbs.twimg.com/media/GHWUdnUXUAAI6Zz.jpg)
Thin film #StructuralColor is widespread in #SlimeMolds (#Myxomycetes, #Amoebozoa): Viola Bauernfeind et al. opg.optica.org/oe/fulltext.cf… #protists

Read and download for FREE 👉 mdpi.com/2079-6412/14/9… 📜 High-Performance and Broad-Viewing-Angle Structural Colored Films with Carbon Black and Carbon Quantum Dot Doping #structuralcolor #photoniccrystals #article #peerreviewed #openaccess #callforreading #mdpi #coatings


Gábor Piszter @euronuclear 🇭🇺 shows how the #structuralcolor of the common blue #butterfly species' #wings affects their behavior, genetic variation and how they can be used in combination with #ALD as biotemplates for #semiconductor surfaces. #BeilsteinNanosurfaces2023

Thanks to @CityUHongKong and @SEBiology for picking up the stories on @amarbiome and @VKamska's nice studies on #structuralcolor. Always fun working with our pal Michael Blumer @imed_tweets and other elasmophiles! cityu.edu.hk/research/stori… eurekalert.org/news-releases/…
eurekalert.org
A New Blue: Mysterious origin of the ribbontail ray’s electric blue spots revealed
Researchers have discovered the unique nanostructures responsible for the electric blue spots of the bluespotted ribbontail ray (Taeniura lymma), with possible applications for developing chemical-...
🎨🌱Structural color provides a greener alternative to chemical textile dyes. Using polycatechin (PCC) nanofilms, this study produces bright, uniform, and controllable colors on silk fabrics through thin-film interference. 🔗 mdpi.com/2313-7673/9/1/… #Textiles #StructuralColor

Thrilled! 🎉 @CroucherHK highlights my #SharkScience postdoc research: blue shark coloration & unique color dynamics! 📷📷 New possibilities for #biomimicry! Thanks @MasonDeanLab & valued collaborators! Read more: croucher.org.hk/en/news/the-ch… #StructuralColor
A thread on how themes from nature are creating new opportunities in optical security & anticounterfeiting. Here are a few examples: holography-news.com/news/2024/nov/… #bioinspired #structuralcolor #nature
holography-news.com
Bio-Inspired Optical Security Design
In last month’s edition of Holography News®, we explored how bio-inspired security threads, showcased at the Global Currency Forum in Oman, are translating the visual complexity of butterflies,...
Discover the fascinating science behind blueberry color. Learn how nature uses structural color for blueberries’ unique blue hue. Find out more with FreeAstroScience. #Blueberry #StructuralColor #Nature #BlueHues #Science #NaturalColors #Fruit Read.. freeastroscience.com/2024/11/why-ar…

光の当て方と角度で色が変わり 色が無くなります #構造色 #StructuralColor #artwork #フラクタル #みんなで楽しむTwitter展覧会 #ART祭 #芸術同盟 #ものづくり ♡いいねありがとうございます


光の当て方と角度で色が変わり 色が無くなります #構造色 #StructuralColor #artwork #フラクタル #みんなで楽しむTwitter展覧会 #ART祭 #芸術同盟 #ものづくり ♡いいねありがとうございます

光の当て方と角度で色が変わり 色が無くなります #構造色 #StructuralColor #artwork #フラクタル #みんなで楽しむTwitter展覧会 #ART祭 #芸術同盟 #ものづくり ♡いいねありがとうございます


View Spotlight Analysis of the #OPG_JOSA_B paper Inverse-designed metasurfaces for highly saturated transmissive colors ow.ly/TNE450R1vOj Spotlight Summary by Filiz Yesilkoy #Metamaterials #StructuralColor

2018年の藝大女子会展の様子です。 #contemporaryart #artwork #StructuralColor #abstract #現代アート #アート好きな人と繋がりたい #絵描きさんと繋がりたい #私の個性はきっと誰かにささる #三億アカウントの中から私を発掘してください #みんなで楽しむTwitter展覧会 #芸術同盟 #芸術の輪

🎉Mingzhu Li group at Institute of Chemistry, CAS, China developed a general multichannel information encryption strategy using a two-dimensional deformable kirigami arranging orientations of the grating arrays by design. #StructuralColor Paper 👉doi.org/10.1016/j.scib…

🎨🌱Structural color provides a greener alternative to chemical textile dyes. Using polycatechin (PCC) nanofilms, this study produces bright, uniform, and controllable colors on silk fabrics through thin-film interference. 🔗 mdpi.com/2313-7673/9/1/… #Textiles #StructuralColor

Via #OPG_OpEx: Tailoring resonant modes in dual cavities for transmissive structural colors with high brightness and high purity bit.ly/4bEYV8N #StructuralColor #SolarCells

Discover the fascinating science behind blueberry color. Learn how nature uses structural color for blueberries’ unique blue hue. Find out more with FreeAstroScience. #Blueberry #StructuralColor #Nature #BlueHues #Science #NaturalColors #Fruit Read.. freeastroscience.com/2024/11/why-ar…

An Editors' Pick via #OPG_OMEx: Photonic spheres by microgel templating [Invited] ow.ly/5FzI50QI30Z #StructuralColor #TemplatedAssembly @unifr
![OpticaPubsGroup's tweet image. An Editors' Pick via #OPG_OMEx: Photonic spheres by microgel templating [Invited] ow.ly/5FzI50QI30Z #StructuralColor #TemplatedAssembly @unifr](https://pbs.twimg.com/media/GHWUdnUXUAAI6Zz.jpg)
Thin film #StructuralColor is widespread in #SlimeMolds (#Myxomycetes, #Amoebozoa): Viola Bauernfeind et al. opg.optica.org/oe/fulltext.cf… #protists

My friend showed me her culture, and I thought I saw something. First time I see #structuralcolor in bacteria live. I would like to transfer this skill to E. coli. Very complex knowledge and engineering are needed and far beyond my current capabilities. I am amazed by its beauty
Structural color. Front and back of a Morpho butterfly. Bought in Cuzco, Peru. #StructuralColor #Biomimetics #interference #optics


Yesterday, I had the pleasure of meeting the students of the Collège St-Michel in Fribourg. My first scientific presentation in French about #StructuralColor in nature was very exciting. Thank you for the interesting questions! @NCCRbioinspired #Aresearcherinyourclass #NCCRWomen



Read and download for FREE 👉 mdpi.com/2079-6412/14/9… 📜 High-Performance and Broad-Viewing-Angle Structural Colored Films with Carbon Black and Carbon Quantum Dot Doping #structuralcolor #photoniccrystals #article #peerreviewed #openaccess #callforreading #mdpi #coatings


Many bright colors in nature are due to structure, not pigment! Now artists & engineers use structural color to create & express - inspired by nature. More on #structuralcolor @novapbs fb.watch/iZ_s52qMW8/ Exhibit #InspiredByNature @kewgardens tinyurl.com/ypfw6jer #sciart

Gábor Piszter @euronuclear 🇭🇺 shows how the #structuralcolor of the common blue #butterfly species' #wings affects their behavior, genetic variation and how they can be used in combination with #ALD as biotemplates for #semiconductor surfaces. #BeilsteinNanosurfaces2023

Something went wrong.
Something went wrong.
United States Trends
- 1. Cowboys 86.1K posts
- 2. Eagles 124K posts
- 3. Rams 21.2K posts
- 4. Stafford 9,135 posts
- 5. #BaddiesUSA 13.2K posts
- 6. Bucs 8,946 posts
- 7. Baker 16.6K posts
- 8. Scotty 5,626 posts
- 9. #RHOP 7,077 posts
- 10. Pickens 26.9K posts
- 11. Raiders 54.1K posts
- 12. Browns 97.9K posts
- 13. Stacey 29.6K posts
- 14. Todd Bowles 1,007 posts
- 15. Davante Adams 2,135 posts
- 16. Shedeur 111K posts
- 17. Nimmo 18.3K posts
- 18. Ceedee 16.3K posts
- 19. Patullo 11.6K posts
- 20. Saquon 7,492 posts




















